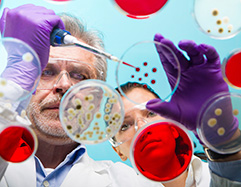

Accounting

Art

Art History
Biology

Business Studies

Chemistry

Chinese

Classical Studies

Commerce

ConnectED – integrated learning

Dance

Design and Visual Communication

Digital Technology

Earth and Space Science

Economics

English

Enterprise Studies

French

Gateway

Geography

German

Health Education

History

Home Economics

Japanese

Kaupapa Māori

Learning Support / Special Education

Legal Studies

Life Skills

Mathematics and Statistics

Media Studies

Music

Pathways Education

Physical Education

Pregnancy and Childcare

Physics

Primary Production (Agriculture / Horticulture)

Samoan

Science

Social Sciences

Spanish

Te Ao Haka

Te Ara Hou Years 7-10

Te Reo Māori

Technology

Tertiary Link and Huarahi